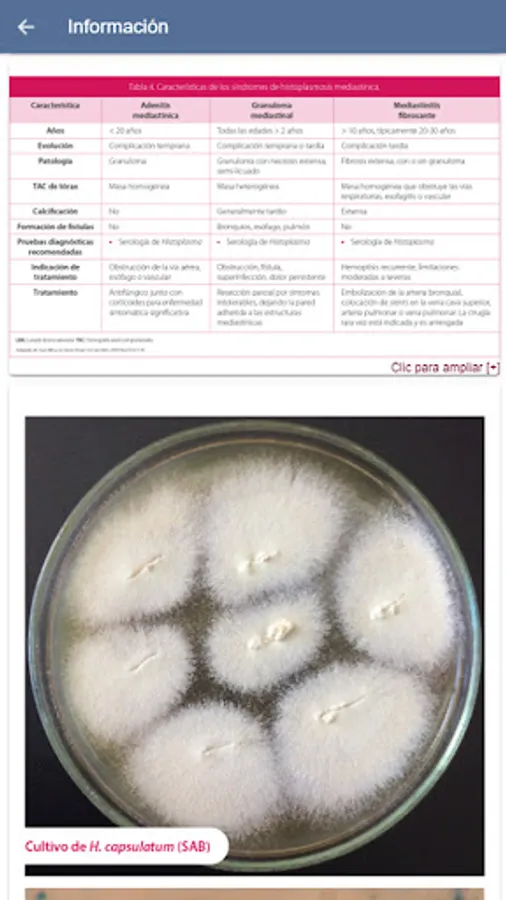

About EFI ACIN
Invasive fungal disease (IFD), caused by opportunistic and emerging yeasts and filamentous fungi, is considered a persistent and growing problem associated with high morbidity and mortality among immunocompromised and critically ill patients.
The objective of the ACIN is to provide a technological support tool for health personnel, which allows the diagnosis and management of IFD, having relevant information at hand, in a clear and concise manner, which helps in the management of patients with disease. invasive
The use of a proven/probable/possible infection case report survey can be considered as a surveillance system and study of the prevalence of infection in high-risk populations, which allows evaluating the evolution of these opportunistic infections throughout the weather
The objective of the ACIN is to provide a technological support tool for health personnel, which allows the diagnosis and management of IFD, having relevant information at hand, in a clear and concise manner, which helps in the management of patients with disease. invasive
The use of a proven/probable/possible infection case report survey can be considered as a surveillance system and study of the prevalence of infection in high-risk populations, which allows evaluating the evolution of these opportunistic infections throughout the weather